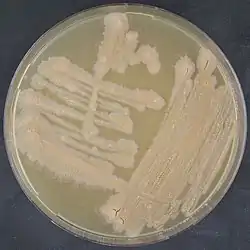

| Tsukamurella tyrosinosolvens | ||
|---|---|---|
![]() Tsukamurella tyrosinosolvens | ||
| Taxonomía | ||
| Dominio: | Bacteria | |
| Filo: | Actinomycetota | |
| Clase: | Actinomycetes | |
| Orden: | Mycobacteriales | |
| Familia: | Tsukamurellaceae | |
| Género: | Tsukamurella | |
| Especie: |
Tsukamurella tyrosinosolvens Yassin et al. 1997 | |
Tsukamurella tyrosinosolvens es una bacteria grampositiva del género Tsukamurella. Descrita en el año 1997. Su etimología hace referencia a la hidrólisis de tirosina.[1] Es aerobia. En agar BHI forma colonias amarillas, secas y rugosas. Crece a 24 y 37 °C, pero no a 45 °C. Resistente a estreptomicina, isoniacida, etambutol, rifampicina, capreomicina y cicloserina. Se aisló a partir de hemocultivos de pacientes con implantes cardíacos y de esputos de pacientes con infecciones pulmonares crónicas.
Clínica
Tras su descripción, se ha aislado esta especie en múltiples ocasiones, siendo actualmente la más predominante del género. Entre las infecciones humanas que puede causar, se encuentran infecciones por catéter,[2][3][4][5] bacteriemia[6][7] y además ha sido aislada de esputos.[8] Por otro lado, se ha descrito un caso como causante de otitis media y absceso cerebral,[9] de conjuntivitis,[10] de queratitis,[8][11][12] neumonía tras trasplante de pulmones[13] y embolismo séptico pulmonar derivado de catéter.[14]
Hábitat
En cuanto a los aislamientos ambientales, se ha encontrado en suelos y del lodo de una planta de tratamiento de aguas,[15] observando que muestra actividad para degradar el ftalato de dibutilo (DBP).[16] En otros estudios se ha observado que tiene cierta actividad como control de la plaga de Phytophtora y un gran potencial en la degradación de alcanos.[17][18] También se ha aislado de animales, como en el grillo topo del sur (Scapteriscus borrellii).[19] Los últimos estudios indican como sinónimo de esta especie a Tsukamurella carboxydivorans,[20] que se aisló en el año 2009 de muestras de suelo en Corea del Sur y posteriormente en suelos contaminados con petróleo en Rumania, mostrando su posible papel en la degradación de alcanos.[21][22]
Referencias
- ↑ Yassin, A. F.; Rainey, F. A.; Burghardt, J.; Brzezinka, H.; Schmitt, S.; Seifert, P.; Zimmermann, O.; Mauch, H. et al. (1997-07). «Tsukamurella tyrosinosolvens sp. nov». International Journal of Systematic Bacteriology 47 (3): 607-614. ISSN 0020-7713. PMID 9226890. doi:10.1099/00207713-47-3-607. Consultado el 13 de agosto de 2022.
- ↑ Liu, Chia-Ying; Lai, Chih-Cheng; Lee, Meng-Rui; Lee, Yi-Chieh; Huang, Yu-Tsung; Liao, Chun-Hsing; Hsueh, Po-Ren (2011-12). «Clinical characteristics of infections caused by Tsukamurella spp. and antimicrobial susceptibilities of the isolates». International Journal of Antimicrobial Agents 38 (6): 534-537. ISSN 1872-7913. PMID 22014886. doi:10.1016/j.ijantimicag.2011.07.018. Consultado el 13 de agosto de 2022.
- ↑ Elshibly, S.; Doherty, J.; Xu, J.; McClurg, R. B.; Rooney, P. J.; Millar, B. C.; Shah, H.; Morris, T. C. M. et al. (2005-05). «Central line-related bacteraemia due to Tsukamurella tyrosinosolvens in a haematology patient». The Ulster Medical Journal 74 (1): 43-46. ISSN 0041-6193. PMC 2475478. PMID 16022132. Consultado el 13 de agosto de 2022.
- ↑ Karunakaran, R.; Halim, H. A.; Ng, K. P.; Hanifah, Y. A.; Chin, E.; Jaafar, F. L.; Abubakar, S. (2011-11). «Tsukamurella tyrosinosolvens intravascular catheter-related bacteremia in a haematology patient: a case report». European Review for Medical and Pharmacological Sciences 15 (11): 1343-1346. ISSN 1128-3602. PMID 22195371. Consultado el 13 de agosto de 2022.
- ↑ Sheridan, Elizabeth A. S.; Warwick, Simon; Chan, Anthony; Dall'Antonia, Martino; Koliou, Maria; Sefton, Armine (1 de marzo de 2003). «Tsukamurella tyrosinosolvens intravascular catheter infection identified using 16S ribosomal DNA sequencing». Clinical Infectious Diseases: An Official Publication of the Infectious Diseases Society of America 36 (5): e69-70. ISSN 1537-6591. PMID 12594657. doi:10.1086/367654. Consultado el 13 de agosto de 2022.
- ↑ Schwartz, M. A.; Tabet, S. R.; Collier, A. C.; Wallis, C. K.; Carlson, L. C.; Nguyen, T. T.; Kattar, M. M.; Coyle, M. B. (1 de octubre de 2002). «Central venous catheter-related bacteremia due to Tsukamurella species in the immunocompromised host: a case series and review of the literature». Clinical Infectious Diseases: An Official Publication of the Infectious Diseases Society of America 35 (7): e72-77. ISSN 1537-6591. PMID 12228839. doi:10.1086/342561. Consultado el 13 de agosto de 2022.
- ↑ Chen, Chang-Hung; Lee, Chao-Tai; Chang, Tsung-Chain (2016). «Tsukamurella tyrosinosolvens bacteremia with coinfection of Mycobacterium bovis pneumonia: case report and literature review». SpringerPlus 5 (1): 2033. ISSN 2193-1801. PMC 5128003. PMID 27995010. doi:10.1186/s40064-016-3707-y. Consultado el 13 de agosto de 2022.
- 1 2 Liu, Chia-Ying; Lai, Chih-Cheng; Lee, Meng-Rui; Lee, Yi-Chieh; Huang, Yu-Tsung; Liao, Chun-Hsing; Hsueh, Po-Ren (2011-12). «Clinical characteristics of infections caused by Tsukamurella spp. and antimicrobial susceptibilities of the isolates». International Journal of Antimicrobial Agents 38 (6): 534-537. ISSN 1872-7913. PMID 22014886. doi:10.1016/j.ijantimicag.2011.07.018. Consultado el 13 de agosto de 2022.
- ↑ Sheng, Wang-Huei; Huang, Yu-Tsung; Chang, Shan-Chwen; Hsueh, Po-Ren (2009-05). «Brain abscess caused by Tsukamurella tyrosinosolvens in an immunocompetent patient». Journal of Clinical Microbiology 47 (5): 1602-1604. ISSN 1098-660X. PMC 2681870. PMID 19297591. doi:10.1128/JCM.01932-08. Consultado el 13 de agosto de 2022.
- ↑ Woo, Patrick C. Y.; Ngan, Antonio H. Y.; Lau, Susanna K. P.; Yuen, Kwok-Yung (2003-07). «Tsukamurella conjunctivitis: a novel clinical syndrome». Journal of Clinical Microbiology 41 (7): 3368-3371. ISSN 0095-1137. PMID 12843095. doi:10.1128/JCM.41.7.3368-3371.2003. Consultado el 13 de agosto de 2022.
- ↑ Leung, Kai Ching Peter; Au, Sunny Chi Lik; Ko, Tak Chuen Simon (2019-10). «Ophthalmic Manifestation of Tsukamurella Species: A Case Series and First Report of Ocular Implant Infection After Enucleation». Cornea 38 (10): 1328-1331. ISSN 1536-4798. PMID 31246677. doi:10.1097/ICO.0000000000001997. Consultado el 13 de agosto de 2022.
- ↑ Woo, Patrick C. Y.; Fong, Angie H. C.; Ngan, Antonio H. Y.; Tam, Dorothy M. W.; Teng, Jade L. L.; Lau, Susanna K. P.; Yuen, Kwok-Yung (2009-06). «First report of Tsukamurella keratitis: association between T. tyrosinosolvens and T. pulmonis and ophthalmologic infections». Journal of Clinical Microbiology 47 (6): 1953-1956. ISSN 1098-660X. PMC 2691093. PMID 19369436. doi:10.1128/JCM.00424-09. Consultado el 13 de agosto de 2022.
- ↑ Ménard, Armelle; Degrange, Sébastien; Peuchant, Olivia; Nguyen, Thi Diem Tien; Dromer, Claire; Maugein, Jeanne (12 de noviembre de 2009). «Tsukamurella tyrosinosolvens--an unusual case report of bacteremic pneumonia after lung transplantation». Annals of Clinical Microbiology and Antimicrobials 8: 30. ISSN 1476-0711. PMC 2780973. PMID 19909497. doi:10.1186/1476-0711-8-30. Consultado el 13 de agosto de 2022.
- ↑ Romano, L.; Spanu, T.; Calista, F.; Zappacosta, B.; Mignogna, S.; Sali, M.; Fiori, B.; Fadda, G. (2011-07). «Tsukamurella tyrosinosolvens and Rhizobium radiobacter sepsis presenting with septic pulmonary emboli». Clinical Microbiology and Infection: The Official Publication of the European Society of Clinical Microbiology and Infectious Diseases 17 (7): 1049-1052. ISSN 1469-0691. PMID 20946410. doi:10.1111/j.1469-0691.2010.03396.x. Consultado el 13 de agosto de 2022.
- ↑ He, Junyao; Yuan, Shuai; Wang, Pu; Wang, Nengqiang (2012-09). «Tsukamurella sp. E105 as a new biocatalyst for highly enantioselective hydrolysis of ethyl 2-(2-oxopyrrolidin-1-yl) butyrate». Journal of Industrial Microbiology & Biotechnology 39 (9): 1261-1268. ISSN 1476-5535. PMID 22555937. doi:10.1007/s10295-012-1132-y. Consultado el 13 de agosto de 2022.
- ↑ Ogawa, Go; Ishida, Masami; Urano, Naoto (2009-08). «Isolation and identification of dibutyl phthalate-degrading bacteria from hydrospheres in Tokyo». The Journal of General and Applied Microbiology 55 (4): 261-265. ISSN 0022-1260. PMID 19700919. doi:10.2323/jgam.55.261. Consultado el 13 de agosto de 2022.
- ↑ Sang, Mee Kyung; Shrestha, Anupama; Kim, Du-Yeon; Park, Kyungseok; Pak, Chun Ho; Kim, Ki Deok (2013-06). «Biocontrol of Phytophthora Blight and Anthracnose in Pepper by Sequentially Selected Antagonistic Rhizobacteria against Phytophthora capsici». The Plant Pathology Journal 29 (2): 154-167. ISSN 1598-2254. PMC 4174781. PMID 25288942. doi:10.5423/PPJ.OA.07.2012.0104. Consultado el 13 de agosto de 2022.
- ↑ Hassanshahian, Mehdi; Ahmadinejad, Mohammad; Tebyanian, Hamid; Kariminik, Ashraf (15 de agosto de 2013). «Isolation and characterization of alkane degrading bacteria from petroleum reservoir waste water in Iran (Kerman and Tehran provenances)». Marine Pollution Bulletin 73 (1): 300-305. ISSN 1879-3363. PMID 23790464. doi:10.1016/j.marpolbul.2013.05.002. Consultado el 13 de agosto de 2022.
- ↑ Aryal, Sudarshan K.; Carter-House, Derreck; Stajich, Jason E.; Dillman, Adler R. (2017-11). «Microbial associates of the southern mole cricket (Scapteriscus borellii) are highly pathogenic». Journal of Invertebrate Pathology 150: 54-62. ISSN 1096-0805. PMID 28916147. doi:10.1016/j.jip.2017.09.008. Consultado el 13 de agosto de 2022.
- ↑ Teng, Jade L. L.; Tang, Ying; Huang, Yi; Guo, Feng-Biao; Wei, Wen; Chen, Jonathan H. K.; Wong, Samson S. Y.; Lau, Susanna K. P. et al. (2016). «Phylogenomic Analyses and Reclassification of Species within the Genus Tsukamurella: Insights to Species Definition in the Post-genomic Era». Frontiers in Microbiology 7: 1137. ISSN 1664-302X. PMC 4955295. PMID 27493643. doi:10.3389/fmicb.2016.01137. Consultado el 13 de agosto de 2022.
- ↑ Park, Sae W.; Kim, Sung M.; Park, Sang T.; Kim, Young M. (2009-06). «Tsukamurella carboxydivorans sp. nov., a carbon monoxide-oxidizing actinomycete». International Journal of Systematic and Evolutionary Microbiology 59 (Pt 6): 1541-1544. ISSN 1466-5026. PMID 19502350. doi:10.1099/ijs.0.005959-0. Consultado el 13 de agosto de 2022.
- ↑ Chiciudean, Iulia; Nie, Yong; Tănase, Ana-Maria; Stoica, Ileana; Wu, Xiao-Lei (20 de febrero de 2018). «Complete genome sequence of Tsukamurella sp. MH1: A wide-chain length alkane-degrading actinomycete». Journal of Biotechnology 268: 1-5. ISSN 1873-4863. PMID 29292131. doi:10.1016/j.jbiotec.2017.12.013. Consultado el 13 de agosto de 2022.